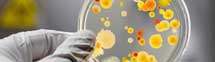
Research

-
Courses
Courses
Choosing a course is one of the most important decisions you'll ever make! View our courses and see what our students and lecturers have to say about the courses you are interested in at the links below.
-
University Life
University Life
Each year more than 4,000 choose University of Galway as their University of choice. Find out what life at University of Galway is all about here.
-
About University of Galway
About University of Galway
Since 1845, University of Galway has been sharing the highest quality teaching and research with Ireland and the world. Find out what makes our University so special – from our distinguished history to the latest news and campus developments.
-
Colleges & Schools
Colleges & Schools
University of Galway has earned international recognition as a research-led university with a commitment to top quality teaching across a range of key areas of expertise.
-
Research & Innovation
Research & Innovation
University of Galway’s vibrant research community take on some of the most pressing challenges of our times.
-
Business & Industry
Guiding Breakthrough Research at University of Galway
We explore and facilitate commercial opportunities for the research community at University of Galway, as well as facilitating industry partnership.
-
Alumni & Friends
Alumni & Friends
There are 128,000 University of Galway alumni worldwide. Stay connected to your alumni community! Join our social networks and update your details online.
-
Community Engagement
Community Engagement
At University of Galway, we believe that the best learning takes place when you apply what you learn in a real world context. That's why many of our courses include work placements or community projects.
Jobs
Jobs
Jobs and Vacancies at NUIG
Join us and you will find yourself in a vibrant, open-minded and friendly environment that is sure to inspire. We employ a diversity of people to support our world-renowned reputation and facilities for teaching and research. Our aim is to provide job satisfaction and all the benefits and opportunities you’d expect from one of the region’s largest and most prestigious employers.
Search and apply for jobs |
|
Academic |
Research |
Support |
Join us and you will find yourself in a vibrant, open-minded and friendly environment that is sure to inspire. We employ a diversity of people to support our world-renowned reputation and facilities for teaching and research. Our aim is to provide job satisfaction and all the benefits and opportunities you’d expect from one of the region’s largest and most prestigious employers.
Human Resources
E hr@nuigalway.ie
T +353 (0)91 492151
Quick Facts

- 17,000 students.
- 2,000 international students from 92 countries.
- 2,400 staff members.
- 120 links with universities across the globe.
- 90,000 alumni in 107 countries.
- 165 years experience providing university education.
NUI Galway is:
- Ireland's top University for student retention - Sunday Times 2011.
- Irelands's top Univerisity for graduate employability with 96% of our graduates employed or in further study within six months of graduating.
- The largest and oldest university in the west of Ireland.
NUI Galway is world leading for research in:
- Biomedical Science and Engineering
- Web Science
- Human Rights
- Marine Science, Energy and Environmental Science
- Applied Social Sciences and Public Policy
Humanities, in particular literature, Theatre and Irish Studies
NUI Galway was awarded the QS Five star rating - 2012